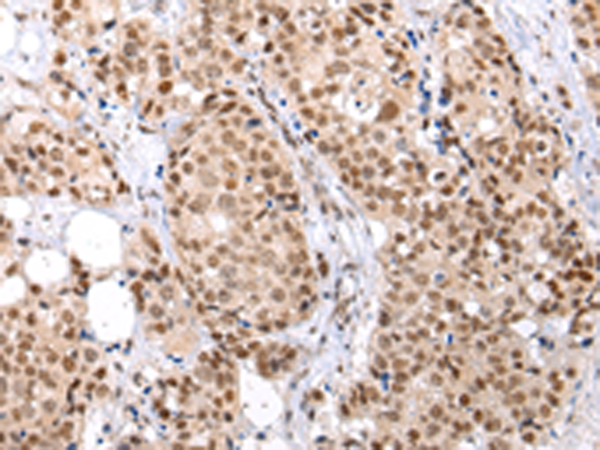

中文名稱: 兔抗BRMS1多克隆抗體
|
Background: |
This gene reduces the metastatic potential, but not the tumorogenicity, of human breast cancer and melanoma cell lines. The protein encoded by this gene localizes primarily to the nucleus and is a component of the mSin3a family of histone deacetylase complexes (HDAC). The protein contains two coiled-coil motifs and several imperfect leucine zipper motifs. Alternative splicing results in two transcript variants encoding different isoforms. |
|
Applications: |
ELISA, IHC |
|
Name of antibody: |
BRMS1 |
|
Immunogen: |
Synthetic peptide of human BRMS1 |
|
Full name: |
breast cancer metastasis suppressor 1 |
|
SwissProt: |
Q9HCU9 |
|
ELISA Recommended dilution: |
2000-5000 |
|
IHC positive control: |
Human breast cancer |
|
IHC Recommend dilution: |
25-100 |
購物車
幫助
021-54845833/15800441009
